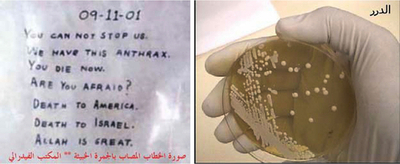
アルカイダ系サイト、炭疽菌テロを呼びかけ、米民間情報機関が公表

戦争・紛争
-

バグダッドで駐留米軍を狙った自爆攻撃、米兵5人が死亡
-

ガザ地区、停戦状態続くもイスラエルは協定の存在否定
-

オーストラリア海軍潜水艦が人員不足、転職者続出で
-

イラク、アフガンの戦闘は米軍に「過度の負担」、調査結果
-

「最大の脅威はイラン、当面の脅威はハマス」、イスラエル情報機関の報告書
-

イラクで腐乱死体100体見つかる、旧フセイン政権時代に殺害か
-

アルカイダ系サイト、炭疽菌テロを呼びかけ、米民間情報機関が公表
-

ユダヤ教神学校の銃乱射、イスラエルで警戒感高まる
-

国連安保理緊急会合、エルサレム銃乱射事件への非難決議採択できず
-

エルサレムのユダヤ教神学校で乱射、学生8人死亡
-

バグダッド中心部で2件の爆弾事件 子どもを含む54人が死亡
-

EU部隊の仏兵、行方不明後にスーダンで死亡
-

スーダンの対日債務、32億円免除へ
-

【図解】緊張高まる南米3か国とFARCの軍事力を比較
-

トルコ軍が再度越境攻撃、PKK発表
-

イラク軍兵士が記者らに暴行、ジャーナリスト団体が国防相に調査求める
-

英国情報機関、第2次世界大戦中に占星術師を雇う
-

前年比大幅増、中国国防予算を徹底解剖